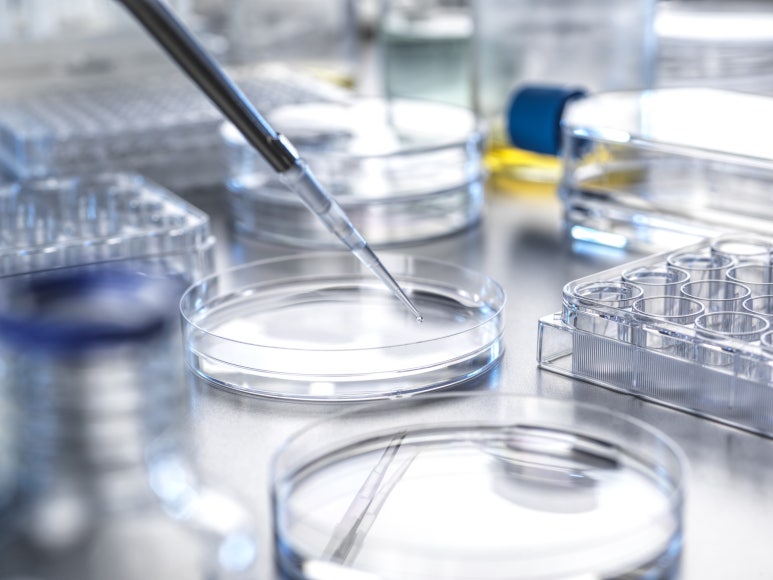
img 1760927950 68f5a0ce78258

생명과학 기업이 글로벌 임상시험을 수행하거나
새로운 시장에 진출할 때,
정확하고 일관된 의학번역은
프로젝트의 성패를 좌우하는 핵심 요소입니다.
그러나 방대한 문서를 빠른 시간 내에,
그리고 비용 효율적으로 처리하는 일은
여전히 업계의 과제로 남아 있습니다.
이때 번역 메모리(Translation Memory, TM)는
의학번역의 품질과 효율성을
동시에 향상시킬 수 있는 핵심 전략으로 주목받고 있습니다.
번역 메모리란 무엇인가요?

번역 메모리(TM)는 과거에 번역된 문장
(원문 언어와 번역 언어 쌍)을 저장하고,
동일하거나 유사한 문장이 다시 나타났을 때
이를 자동으로 제안하는 기술입니다.
의학번역에서는 다음과 같은 반복 콘텐츠가
자주 등장합니다
의약품 설명서
임상시험 계획서
시험대상자 동의서
이상 사례 보고서
이러한 반복 문장은 TM을 통해 재번역 없이
처리할 수 있어 번역 일관성을 유지하고
품질 향상은 물론 작업 속도와
비용 절감에도 기여합니다.
생명과학 분야에서 TM의 활용

생명과학 제품은 개발, 규제 제출, 상업화까지
각 단계별로 철저하게 문서화되어야 합니다.
예를 들어 임상시험 1상부터 3상까지 진행되는 동안,
임상시험 개요, 용량, 투약 일정, 이상사례 등
유사한 문장이 반복적으로 등장합니다.
TM을 도입하면 다음과 같은 장점이 있습니다
표현 일관성 확보: 여러 프로젝트에 걸쳐 동일한 용어와 표현 사용
작업 시간 단축: 번역 작업의 효율 증가
문서 간 연결성 확보: 기존 TM 데이터 기반으로 새로운 프로젝트에 활용 가능
저비용 시장에서 TM 도입이 특히 중요한 이유

초기 번역 예산이 부족한 신흥국 시장 또는
소규모 임상 프로젝트의 경우,
TM 도입을 망설일 수 있습니다.
그러나 실제로는 TM이 장기적인 비용을
절감할 뿐 아니라, 내부 품질 관리와
보안 유지 측면에서도 뛰어난 효과를 발휘합니다.
예를 들어 임상시험 보고서, 규제 제출 문서처럼
유사 구조를 가진 문서들이 반복적으로 생성되는
환경에서는 TM의 활용 가치가 더욱 큽니다.
TM을 기반으로 한 의학번역 파트너 선정 시 고려할 요소
언어 서비스 제공업체(LSP)와 협업할 때는
단순히 번역 속도나 단가가 아닌 다음 요소들을
종합적으로 고려해야 합니다
정확성: 환자 안전과 직접 연결된 문서의 경우,
오역은 치명적인 결과를 초래할 수 있습니다.
납기 준수: 규제기관 제출 일정 등 시간 제약이 많은 프로젝트에서 빠른 대응 능력은 필수입니다.
TM 기반의 일관성: 특히 현지 리뷰(Regional Review) 과정이 중요한 아시아태평양(APAC) 지역에서는 TM을 통해 표현 일관성을 확보하고 검토 시간을 단축할 수 있습니다.
보안 및 데이터 보호 수준: 기밀 임상 정보 보호를 위한 ISO 인증 및 보안 프로토콜 여부도 확인해야 합니다.
번역 메모리(Translation Memory)는
단순한 번역 보조 도구가 아닙니다.
생명과학 기업의 글로벌 전략에 있어 의학번역의
품질 보장, 시간 단축, 비용 효율성을
동시에 실현할 수 있는 핵심 인프라입니다.
특히 문서량이 방대하고 반복률이 높은
임상시험 및 의약품 등록 업무에서는
TM의 효율성이 극대화됩니다.
글로벌 진출을 준비 중이거나,
번역 품질과 일정 모두를 중요하게 생각하는
조직이라면, TM 기반 번역 전략과 전문 LSP와의
협업은 더 이상 선택이 아닌 필수입니다.
정확하고 일관된 의학번역 솔루션이 필요하신가요?
지금 무료 번역 컨설팅을 신청하고, 귀사의 프로젝트에 가장 적합한 언어 전략을 제안받아보세요.





